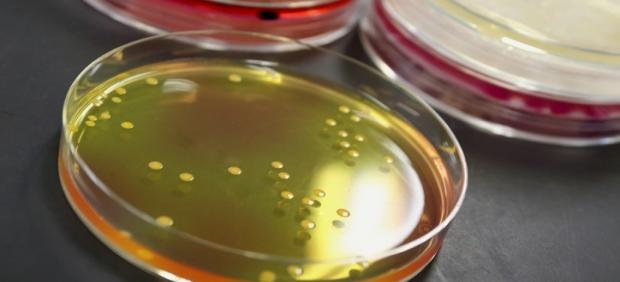
Clostridium botulinum, botulismo

20MINUTOS.ES
- Los botes de conservas son su hábitat favorito.
- Entre las 18 y 36 horas tardan en aparecer los síntomas, como problemas respiratorios, vómitos, o diarrea.
- A simple vista no se puede saber si un alimento está infectado, ya que la toxina no afecta a su sabor, olor ni color.
- Alerta sanitaria por un brote de intoxicación alimentaria provocada por el atún de la marca DIA.
Las alertas sanitarias no paran en los últimos coletazos del verano. A la emergencia por el brote de listeria se ha sumado en las últimas horas el aviso del ministerio de Sanidad por un brote de intoxicación alimentario provocado por unos enlatados de atún de la marca DIA, elaborados en la empresa Frinsa del Noroeste S.A., en los que se ha detectado la toxina botulínica. Pero ¿qué es el botulismo, dónde suele aparecer, cuáles son sus síntomas y cómo podemos detectar sus síntomas?
¿Qué es el botulismo?
En primer lugar hay que dejar claro que el botulismo es una enfermedad grave y que puede llegar a ser mortal. La contaminación viene producida por el germen Clostridium botulinum, capaz de elaborar la toxina de la que hablamos y que, según el portal de salud de La Rioja, «es uno de los venenos más activos que se conocen y que permanece en el alimento sin alterarlo a simple vista». Uno enferma cuando ingiere el alimento infectado.
¿Dónde suele aparecer?
Los botes de conservas, sobre todo caseras, son el lugar donde mayor peligro representan para la ciudadanía. Un mal tratamiento del recipiente nos puede pegar un buen susto. Según la Comunidad de Madrid «principalmente en conservas como guindillas en aceite, espárragos, alubias verdes, etc.» y «se asocia a alimentos poco ácidos (con pH por encima de 4.5)».
Síntomas
Los síntomas de haber contraído el botulismo suelen aparecer entre las 18 y las 36 horas tras haber ingerido el alimento contaminado. Las señales son: paralización de músculos, aparición de problemas respiratorios y, en el peor de los casos, la parada cardiorrespiratoria. La visión borrosa o doble, cansacio, vómitos y diarrea también pueden aparecer.
¿Como detectarlo?
Imposible para el consumidor. No se detecta a simple vista.